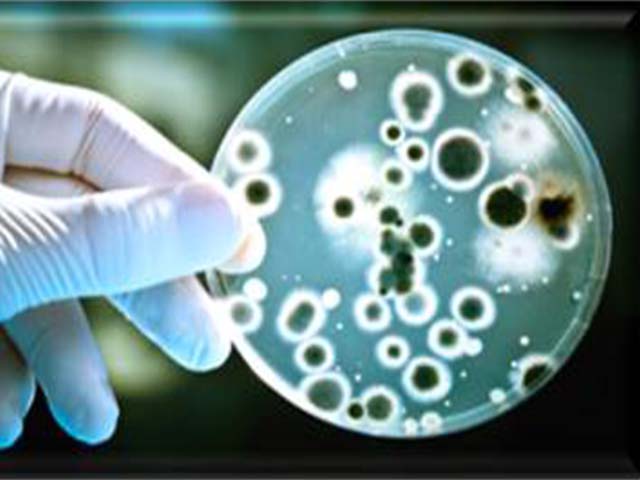
robotic slider

Patent


Patent Granted
NOVEL MATERIAL FOR ELECTRO-ADHESIVE MATERIALS, PRODUCTS THEREOF AND METHOD OF MANUFACTURE
INVENTORS: Dr.S.RAJESH, Dr. R. NANDHAKUMAR, Dr.B.VIDHYA, Dr.A.SAKUNTHALA
Lighter and affordable Exosuits / Exoskeletons augments the differently abled persons to do their activities at ease
The team has developed light weight electroadhesive clutch which has a robust performance for the operation of Exosuits/Exoskeletons and Artificial Intelligence & IoT enabled VIRTUAL REALITY haptic gloves in any environment.

Patent Certificate
Patent File no. 202041052409
A POLYMERIC NANOFABRIC MATERIAL TO PREVENT MICROBIAL PATHOGENS
Published 31.7.2020 File. No 202041031484

NOVEL MATERIAL FOR ELECTRO-ADHESIVE MATERIALS, PRODUCTS THEREOF AND METHOD OF MANUFACTURE
Published 11.12.2020 File.No. 202041052409

LITHIUM TRIVANADATE THIN FILM NANORODS BY PULSED LASER DEPOSITION TECHNIQUE
Published 8.1.2021 File.No 202041024467

A MICROBIAL FUEL CELL FOR GENERATING ELECTRICITY FROM WASTEWATER
Under examination 26.5.2020 File.No202041021896

DECOLOURING AND DYE REMOVAL AGENT
Under examination 5.3.2021 File.No 202041024472

